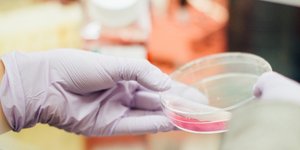

ΠΑΓΚΡΕΑΣ
OΛΕΣ ΟΙ ΕΙΔΗΣΕΙΣ ΚΑΙ ΤΑ ΤΕΛΕΥΤΑΙΑ ΝΕΑ ΓΙΑ ΤΟ TAG ΠΑΓΚΡΕΑΣ



ΥΓΕΙΑ 09/03/2022 08:53
Νέα μέθοδος για την έγκαιρη διάγνωση του καρκίνου του παγκρέατος

ΥΓΕΙΑ 25/01/2022 11:53
Παθήσεις παγκρέατος: Σύγχρονες θεραπείες και ρομποτική τεχνολογία